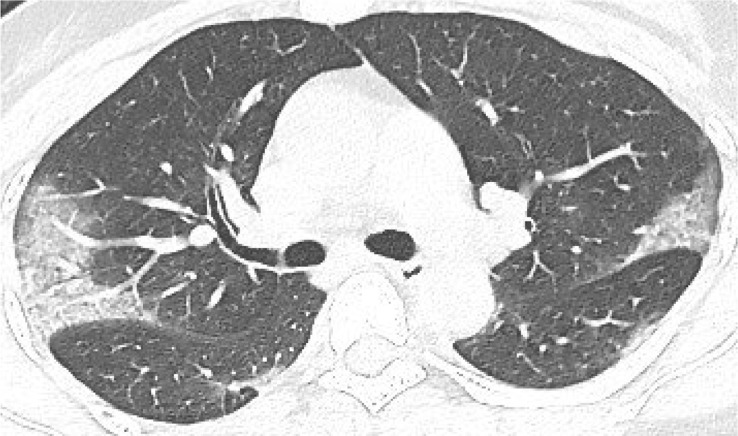
Fig. 2

Abstract
On December 31, 2019, the Wuhan Health Commission reported the discovery of an “unexplained” pneumonia for the first time; the pathogen was confirmed as novel coronavirus pneumonia (2019-nCoV) on January 7, 2020. As one of the important examination methods for the coronavirus diseases 2019 (COVID-19), Computed Tomography (CT) examination plays an important role in the clinical discovery of suspected cases, diagnosis, and treatment review. This paper reviews the published papers in order to offer help in early clinical screening, disease diagnosis, disease severity determination and post-treatment review.
Keywords: 2019-nCoV, COVID-19, CT features, Differential diagnosis
On December 31, 2019, the Wuhan Health Commission first reported the discovery of “unexplained” pneumonia [1]. The pathogen was confirmed as novel coronavirus (2019-nCoV) on January 7, 2020 [2]. On 11 February 2020, the World Health Organization (WHO) named the novel coronavirus pneumonia Corona Virus Disease 2019 (COVID-19) [3]. COVID-19, first reported in Wuhan, has spread around the world, and multiple countries have reported cases.
With the increasing number of false negative cases of the nucleic acid test in the pharyngeal swab, it is realized that the novel coronavirus is highly occult, and the nucleic acid test in the pharyngeal swab itself has limitations. According to the study of AI et al. [4], 48% of patients with negative nucleic acid test remained highly suspicious of COVID-19 on CT, and 33% were suspicious of COVID-19. In addition, during the follow-up of the cases, 42% of the cases had chest CT improvement prior to nucleic acid detection and negative transformation. According to the “Notice on the issuance of a program for the diagnosis and treatment of 2019-nCoV infected pneumonia (Trial Version 5)” [5] of the General Office of China's National Health Committee, “Clinical diagnosis cases” were added in Hubei Province, and cases in which nucleic acid test was negative, but whose clinical manifestations, epidemiological and pulmonary imaging manifestations were consistent with the COVID-19 were considered as clinical diagnosis cases. The control and isolation of clinically diagnosed cases can greatly control the sources of infection, cut off the possible routes of virus infection, and prevent the occurrence of large numbers of family gathering cases caused by home isolation of potentially infected people. The use of chest CT during the follow-up can quickly assess the changes of the patient's condition. Therefore, it is very important to understand the imaging features and dynamic changes of pneumonia caused by 2019-nCoV. CT examination, as one of the important means for the examination of COVID-19, plays an important role in the clinical discovery of suspected cases, diagnosis, and treatment review. This paper reviews the published papers in order to provide practical help in early clinical screening, disease diagnosis, disease severity assessment and post-treatment review.
1. Epidemic characteristics
COVID-19 is clearly characterized by human-to-human transmission [6]. The main source of infection is patients with COVID-19, asymptomatic infection may also become the source of infection. The infectivity of patients in the incubation and recovery period remains to be determined. Transmission by respiratory droplets and contact are the main routes of transmission, which is possible when exposed to high concentrations of aerosol for a long time in a relatively closed environment. Based on the current epidemiological investigation, the incubation period is 1–14 days, with the majority occurring in 3–7 days. The general public is generally susceptible. Hospital-related transmission is a possible infection mechanism for both medical personnel and inpatients [7].
2. Clinical manifestations and laboratory tests
Multiple studies [1,7,8] have shown that the clinical manifestations of patients with COVID-19 are mainly fever, fatigue and dry cough, with fewer symptoms such as nasal congestion, runny nose, sore throat and diarrhea. In severe cases, dyspnea and/or hypoxemia usually occur one week after the onset of the disease. In severe patients, acute respiratory distress syndrome, septic shock, difficult to correct metabolic acidosis, and coagulation dysfunction develop rapidly. In the course of severe or critical illness, the patient may have moderate or low fever, or even no obvious fever. Mild patients can only show low fever, mild fatigue, no pneumonia. At present, most patients have a good prognosis and a few are in critical condition. The elderly and those with chronic diseases have poor prognosis while in children, the symptoms are relatively mild.
In the early stage of the disease, the total number of peripheral blood leukocytes was normal or decreased, and the lymphocyte count was decreased. In some patients, liver enzymes, lactate dehydrogenase (LDH), myoglobin and myoglobin were increased. Increased troponin is seen in some critical patients. In most patients, c-reactive protein (CRP) and serum sedimentation were increased, and procalcitonin was normal. In severe cases, D-dimer was increased, peripheral blood lymphocytes were progressively decreased, and inflammatory factors were often increased in severe and critical patients. Novel coronavirus nucleic acid can be detected in nasopharyngeal swabs, sputum, lower respiratory tract secretions, blood, feces and other specimens.
3. Imaging findings
3.1. Imaging manifestations
According to the guideline [9], CT examination is strongly recommended as a test for COVID-2019. According to the guidelines, the typical image of COVID-2019 presents multiple patchy ground glass opacity (GGO) along the subpleural and bronchovascular bundles in both lungs, separated by meshed or thickened lobular septa as crazy-paving pattern (54.2%) (Fig. 1, Fig. 2, Fig. 3, Fig. 4 ) and multiple patchy or large patchy consolidation in both lungs (Fig. 5 ), with thickening of interlobular septa, mainly in the middle and lower lobes (31.3%). It is consistent with the findings of Wang's [7] review of 138 cases (the CT findings of all cases involved both lungs), Huang's [1] review of 41 cases (all cases involved both lungs) and Song's [8] review of 51 cases (distribution: the lesions involved both lungs in 86% of patients, the lower lobe in 90% of patients, and the peripheral lung field in 86% of patients; density: 39% of the total number of lesions showed as GGO with reticular and/or interlobular septal thickening). Atypical images showed single lesion [10] (Fig. 6 ) and single or multiple consolidation nodules in the center of lobules, surrounded by ground glass opacities [9]. Both Song [8] and Pan [11] found that COVID-19 rarely caused mediastinal lymphadenopathy or pleural effusion.
Fig. 1.
39-year old male with dry cough for 5 days. Nucleic acid test: positive. Imaging examination: CT showed diffuse patchy GGO with crazy-paving pattern along the subpleural in both lungs.
Fig. 2.
40-year old female with intermittent fever (maximum temperature of 38 °C) for 1 week. Nucleic acid test: positive. Imaging examination: CT showed multiple patchy GGO with crazy-paving pattern along the subpleural in both lungs.
Fig. 3.
83-year old female with intermittent fever (maximum temperature of 38.8 °C) for 1 week. Nucleic acid test: positive. Imaging examination: CT showed diffuse patchy GGO with crazy-paving pattern in both lungs.
Fig. 4.
67-year old female with cough and sputum for half a month. Nucleic acid test: positive. Imaging examination: CT showed diffuse patchy GGO and consolidation with crazy-paving pattern in both lungs.
Fig. 5.
51-year old female with intermittent fever (maximum temperature of 37.7 °C) for 1 week. Nucleic acid test: positive. Imaging examination: CT showed patchy consolidation along the subpleural in both lungs.
Fig. 6.
43-year old male with intermittent fever (maximum temperature of 39.5 °C) for 1 week. Nucleic acid test: positive. Imaging examination: CT showed a single mixed GGO nodule in the lower lobe of right lung.
Song et al. [8] found that older patients had more lung lobe involvement and more consolidation than younger patients. Wang et al. [7] found that elderly patients have weak resistance, and at the same time, they are combined with underlying diseases, and they are prone to progress to severe or critical type. Ma et al. [12] found that mild and common cases were more common in children, and both clinical and imaging manifestations were milder than in adults.
3.2. Dynamic change of image
Pan et al. [11] studied the evolution of chest CT for a total of 82 times in 21 non-severe patients. According to the quartile of the patients and the degree of lung involvement from day 0 to day 26 after the onset, the four stages from the first symptom were determined. ① Early stage (1–4 days after the onset of the initial symptom, n = 24): ground glass opacity was showed in the subpleural parts of both lungs or single lung lower lobe; ② Progressive stage (5–8 days after the onset of the initial symptom, n = 17): the lesions expanded to a bilateral multi-lobe distribution with diffuse GGO, crazy-paving pattern and consolidation; ③ Peak stage (9–13 days after the onset of the initial symptom, n = 21): the involved area slowly increased to peak involvement and consolidation became more prevalent. ④ Absorption stage (≥14 days after the onset of the initial symptom, n = 20): the consolidation was gradually absorbed.
In most patients who recovered from COVID-19, the involvement range of pulmonary lesions reached a peak and then gradually decreased 10 days after the onset of the initial symptom. The guidelines [9] reviewed the chest CT data of 83 patients: ① Ultra-early stage (patients without clinical manifestation, negative laboratory test but positive throat swab for 2019-nCoV, 8.4% in a total of 83 cases). The main imaging manifestations were single, double or scattered focal ground glass opacity, nodules located in central lobule surrounded by patchy ground glass opacities, patchy consolidation with air-bronchogram, which was mainly distributed in the middle and lower pleura. ② Early stage (1–3 days after the onset of the initial symptom, 54.2% in a total of 83 cases). Single or multiple scattered patchy or agglomerated ground-glass opacities were showed, separated by honeycomb-like or grid-like thickened of interlobular septa. ③ Rapid progression stage (3–7 days after the onset of the initial symptom, 20.5% in a total of 83 cases). The CT findings were a fusion of large, light consolidation with air bronchogram. ④ Consolidation stage (7–14 days after the onset of the initial symptom, 31.2% in a total of 83 cases). CT imaging showed multiple patchy consolidation, and the range was slightly smaller than that of the previous stage. ⑤ Dissipation stage (2–3 weeks after the onset of the initial symptom, 20.5% in a total of 83 cases). The CT findings were patchy consolidation or strip-like opacity. As time goes on, it showed grid-like thickening of interlobular septa, thickening and strip-like twist of bronchial wall and a few scattered patchy consolidations. Shi et al. [13] divided 81 patients into 4 groups according to the interval between initial symptoms and CT examination. ① Group 1 (patients without symptoms, n = 15) mainly presented unilateral (60%), polycentric (53%) ground glass opacity (93%); ② Group 2 (within 1 week of symptom onset, n = 21) mainly presented bilateral (90%), diffuse (52%) ground glass opacity (81%). ③ Group 3 (more than 1 week less than 2 weeks after the onset of the initial symptom, n = 30) showed ground glass opacity (57%) reduced, consolidation and mixed lesions appeared (40%). ④ Group 4 (more than 2 weeks less than 3 weeks after the onset of the initial symptom, n = 15) showed that consolidation and mixed lesions (53%) were the main features and ground glass opacity (33%) continued to reduce. All of the above studies indicated that, with the progression of disease, the lesions tended to be both-lungs and diffuse distribution and the ground glass opacity gradually decreased, while the consolidation shadow gradually increased (Fig. 7, Fig. 8 ).
Fig. 7.
41-year old male. A, CT shows no obvious abnormalities in both lungs; B, five days later, CT shows new GGO in the lower lobes of both lungs.
Fig. 8.
56-year old female. A, CT shows ground glass opacity both lungs; B, five days later, CT shows ground glass opacity decreased and consolidation increased.
4. Differential diagnosis
COVID-19 is mainly differentiated from other known viral pneumonia such as influenza virus, parainfluenza virus, adenovirus, respiratory syncytial virus, rhinovirus, human partial pneumonovirus, SARS coronavirus, and mycoplasma pneumoniae, chlamydia pneumoniae and bacterial pneumonia, an additionally from non-infectious diseases, such as vasculitis, dermatomyositis and mechanical pneumonia. In this paper, COVID-19 was differentiated from some common and easily confused infectious diseases.
4.1. Differentiation from other viral pneumonia
4.1.1. SARS
In the early stage of SARS, chest CT showed small flaky ground glass opacity in the lungs, and the distribution of the lower lobes and surrounding areas was more common. The disease became progressively worse within 3–7 days after onset, and progressed to a progressive stage 2–3 weeks after onset. It showed increased density of lesions, which could be combined with lobular septal thickening. The range of lesions was enlarged and the single lesion progressed to multiple or diffuse lesions. 2–3 weeks after the onset of the disease, the lung lesions entered the absorption phase, the lesions gradually became localized, the density began to decrease and the scope gradually shrank or even disappeared [[14], [15], [16]].
4.1.2. H1N1 influenza
Chest CT findings of H1N1 influenza: ① In the early stage, ground glass opacity and consolidation were scattered in the lung in small pieces, distribution of subpleural or along the bronchovascular bundled; ② In the progressive stage, pulmonary infection reached the most serious stage within 8–14 days of the onset. The ground glass opacity could be fused into scattered consolidation, and the air bronchogram could be seen in it. ③ In the recovery stage, lung lesions were mainly interstitial lung lesions. Some may be accompanied by mediastinal lymphadenopathy, pleural effusion, mediastinal emphysema, etc [17].
4.1.3. H7N9 avian influenza
The CT findings of H7N9 showed that in the early stage, pulmonary lesions were mainly flaky consolidation and were often located in the unilateral lower lobe or the lower lobes of both lungs. Pulmonary lesions could rapidly develop into diffuse lesions with multiple lobes and segments in both lungs within 3–7 days after onset. And ground glass opacity in the progressive stage is the main characteristic of H7N9. Lesions in the right lung were often more severe than those in the left lung. The lesions in the lower lobe and the posterior part of both lungs were more serious and showed the characteristics of gravity distribution. H7N9 was often infected with other bacteria and the imaging findings were complex and varied. The recovery period was long, which was manifested by pulmonary interstitial fibrosis [18].
4.2. Differential diagnosis of non-viral infectious pneumonia [19]
4.2.1. Mycoplasma pneumonia
Mycoplasma pneumonia was common in children. CT findings were central lobular nodules, GGO, consolidation, bronchial wall thickening and sign of tree-in-bud. Hilar lymph nodes were often enlarged.
4.2.2. Bacterial pneumonia
Patients with the disease cough purulent, bloody or rust-colored sputum, the white blood cell count often increases, imaging findings are mostly segmental consolidation and antibiotics treatment is effective.
5. Problem
As this disease is a new disease, few relevant literatures have been published; furthermore, the follow-up time of clinical cases is short and long-term observation of cases is lacking. In addition, so far, only a few death cases have undergone autopsy and there is still a lack of relevant pathological literature, so it is impossible to accurately correspond the imaging findings with the pathological findings.
Ethic statement
The ethic committees in our hospitals approved this research (approval number, 2020015). All enrolled subjects agreed to participate in this research, and written informed consent was obtained from the enrolled subjects prior to the investigation.
Conflict of interest
None.
Footnotes
Peer review under responsibility of Beijing You'an Hospital affiliated to Capital Medical University.
References
- 1.Huang C., Wang Y., Li X., Ren L., Zhao J., Hu Y., et al. Clinical features of patients infected with 2019 novel coronavirus in Wuhan, China. Lancet. 2020;395(10223):497–506. doi: 10.1016/S0140-6736(20)30183-5. [DOI] [PMC free article] [PubMed] [Google Scholar]
- 2.Zhu N., Zhang D., Wang W., Li X., Yang B., Song J., et al. A novel coronavirus from patients with pneumonia in China, 2019. N Engl J Med. 2020;382(8):727–733. doi: 10.1056/NEJMoa2001017. [DOI] [PMC free article] [PubMed] [Google Scholar]
- 3.WHO . World Health Organization; Gevena: 2020. Clinical management of severe acute respiratory infection when novel coronavirus infection is suspected. 2020 [EB/OL] [Google Scholar]
- 4.Ai T., Yang Z., Hou H., Zhan C., Chen C., Lv W., et al. Correlation of chest CT and RT-PCR testing in coronavirus disease 2019 (COVID-19) in China: a report of 1014 cases. Radiology. 2020;296(2):E32–E40. doi: 10.1148/radiol.2020200642. [DOI] [PMC free article] [PubMed] [Google Scholar]
- 5.General Office of National Health Committee . 2020-02-05. Notice on the issuance of a program for the diagnosis and treatment of novel coronavirus (2019-nCoV) infected pneumonia (Trial Version 5)http://www.nhc.gov.cn/yzygj/s7653p/202002/3b09b894ac9b4204a79db5b8912d4440.shtml [EB/OL] [Google Scholar]
- 6.Chan J.F., Yuan S., Kok K., To K.K., Chu H., Yang J., et al. A familial cluster of pneumonia associated with the 2019 novel coronavirus indicating person-to-person transmission: a study of a family cluster. Lancet. 2020;395(10223):514–523. doi: 10.1016/S0140-6736(20)30154-9. [DOI] [PMC free article] [PubMed] [Google Scholar]
- 7.Wang D., Hu B., Hu C., Zhu F., Liu X., Zhang J., et al. Clinical characteristics of 138 hospitalized patients with 2019 novel coronavirus–infected pneumonia in Wuhan, China. J Am Med Assoc. 2020;323(11):1061–1069. doi: 10.1001/jama.2020.1585. [DOI] [PMC free article] [PubMed] [Google Scholar]
- 8.Song F., Shi N., Shan F., Zhang Z., Shen J., Lu H., et al. Emerging coronavirus 2019-nCoV pneumonia. Radiology. 2020;295(1):210–217. doi: 10.1148/radiol.2020200274. [DOI] [PMC free article] [PubMed] [Google Scholar]
- 9.Jin Y., Cai L., Cheng Z., Cheng H., Deng T., Fan Y., et al. A rapid advice guideline for the diagnosis and treatment of 2019 novel coronavirus (2019-nCoV) infected pneumonia (standard version) Military Medical Research. 2020;7(1):4. doi: 10.1186/s40779-020-0233-6. [DOI] [PMC free article] [PubMed] [Google Scholar]
- 10.Wang W., Hu H., Song L., Gong X., Qu Y., Lu Z. Image of pulmonary and diagnosis of atypicalnovel coronavirus (2019-nCoV) infected pneumonia: case series of 14 patients. Yixue Xinzhi. 2020;30(1):7–9. [Article in China] [Google Scholar]
- 11.Pan F., Ye T., Sun P., Gui S., Liang B., Li L., et al. Time course of lung changes on chest CT during recovery from 2019 novel coronavirus (COVID-19) pneumonia. Radiology. 2020;295(3):715–721. doi: 10.1148/radiol.2020200370. [DOI] [PMC free article] [PubMed] [Google Scholar]
- 12.Ma H., Shao J., Wang Y., Zhai A., Zheng N., Li Q., et al. High resolution CT features of novel coronavirus pneumonia in children. Chin J Radiol. 2020 doi: 10.3760/cma.j.issn.1005-1201.2020.0002. [Article in China] [DOI] [Google Scholar]
- 13.Shi H., Han X., Jiang N., Cao Y., Alwalid O., Gu J., et al. Radiological findings from 81 patients with COVID-19 pneumonia in Wuhan, China: a descriptive study. Lancet Infect Dis. 2020;20(4):425–434. doi: 10.1016/S1473-3099(20)30086-4. [DOI] [PMC free article] [PubMed] [Google Scholar]
- 14.Wong K.T., Antonio G.E., Hui D.S.C., Lee N., Yuen E.H.Y., Wu A., et al. Thin-section CT of severe acute respiratory syndrome: evaluation of 73 patients exposed to or with the disease. Radiology. 2003;228(2):395–400. doi: 10.1148/radiol.2283030541. [DOI] [PubMed] [Google Scholar]
- 15.Ooi G.C., Khong P.L., Müller N.L., Yiu W.C., Zhou L.J., Ho J.C.M., et al. Severe acute respiratory syndrome: temporal lung changes at thin-section CT in 30 patients. Radiology. 2004;230(3):836–844. doi: 10.1148/radiol.2303030853. [DOI] [PubMed] [Google Scholar]
- 16.Wong K.T., Antonio G.E., Hui D.S.C., Lee N., Ahuja A.T. Severe acute respiratory syndrome: radiographic appearances and pattern of progression in 138 patients. Radiology. 2003;228(2):401–406. doi: 10.1148/radiol.2282030593. [DOI] [PubMed] [Google Scholar]
- 17.Aviram G., Bar-Shai A., Sosna J., Rogowski O., Rosen G., Weinstein I., et al. H1N1 influenza: initial chest radiographic findings in helping predict patient outcome. Radiology. 2010;255(1):252–259. doi: 10.1148/radiol.10092240. [DOI] [PubMed] [Google Scholar]
- 18.Wang Q., Zhang Z., Shi Y., Jiang Y. Emerging h7n9 influenza a (novel reassortant avian origin) pneumonia: radiologic Findings. Radiology. 2013;268(3):882–889. doi: 10.1148/radiol.13130988. [DOI] [PubMed] [Google Scholar]
- 19.Li H., Xu H. Guideline for imaging diagnosis of novel coronavirus(2019-nCoV) infected pneumonia(1st edition 2020) Yixue Xinzhi. 2020;30(1):22–34. [Google Scholar]